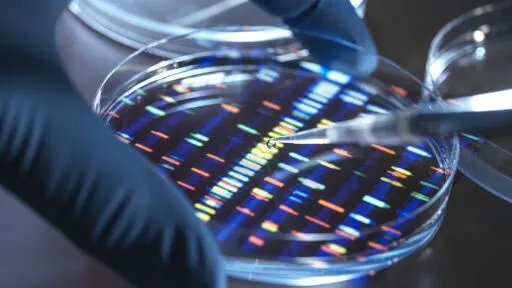

Scientists can 'play God' by building human DNA from scratch
Scientists can 'play God' by building human DNA from scratch
www.dailymail.co.uk
Scientists can 'play God' by building human DNA from scratch

Scientists can 'play God' by building human DNA from scratch
Scientists can 'play God' by building human DNA from scratch